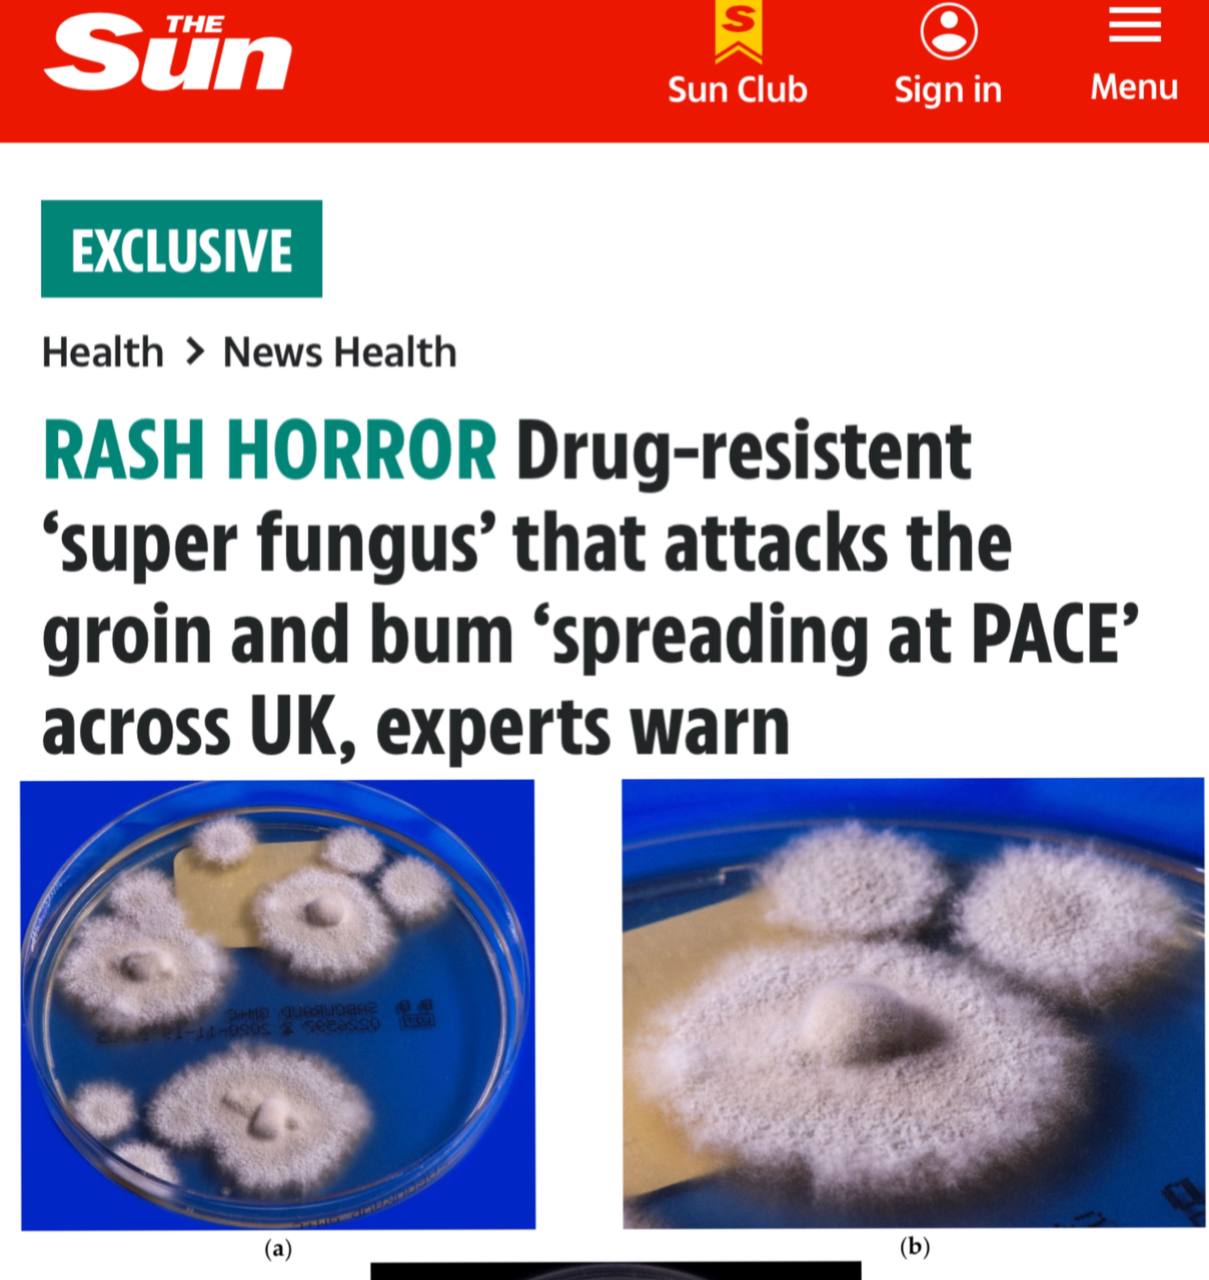
В Европе распространяется опасный супергрибок По данным The Sun его название Trichophyton indotineae Инфекция вызывает красные зудящие высыпания в основном в паху на бедрах и ягодицах За последние три года число случаев заражения увеличилось почти на 500 Trichophyton indotineae передается как путем прямого контакта с больным человеком так и через грязные поверхности Заболевание не опасно для жизни но его очень трудно лечить и больным приходится проходить курсы терапии по нескольку недель или даже месяцев Инфекция уже активно передается по территории Британии Франции и Германии а также зафиксированы случаи заражения в США По словам эксперта по инфекционным заболеваниям Манчестерского университета Дэвида Деннинга это станет большой проблемой во всем мире Подписаться на URA RU мы в MAX

26 ноября, 18:48
В Европе фиксируется рост случаев заражения супергрибком Trichophyton indotineae


РЕН ТВ|Новости
Новый штамм грибковой инфекции поражающей пах и ягодицы распространяется по Европе Называется он Trichophyton indotineae сообщает издание Daily Star Инфекция поражает паховую область и ягодицы а за последние три года число заболевших выросло примерно на 500 Штамм устойчив к обычным лекарствам и передается через прямой контакт с зараженным например во время интимной близости Среди первичных симптомов кольцевидные пятна на паху или ягодицах Инфекция является тяжелой разновидностью лишая Грибок уже активно передается по территории Британии а также зафиксированы случаи заражения в США Франции и Германии РЕН ТВ в Telegram в MAX
Наука89 дней назад

360 новости
В странах Европы начал стремительно распространяться чрезвычайно устойчивый к лечению опасный грибок Trichophyton indotineae Его уже начали называть супергрибком Об этом сообщила газета The Sun Trichophyton indotineae вызывает красные зудящие высыпания в основном в паху на бедрах и ягодицах указано в материале За последние три года в Великобритании число случаев заражения супергрибком увеличилось почти на 500 Инфекция распространяется во время прямого контакта с инфицированным человеком а также через загрязненные поверхности предметы в быту или половым путем пишет Life Заболевание не опасно для жизни но его очень трудно лечить Заразившимся людям приходится проходить курсы терапии по нескольку недель или даже месяцев Только за последние десять лет грибковая инфекция распространилась более чем в 20 странах в том числе в США и Германии
Наука89 дней назад


Абзац
Супергрибок захватывает Европу почему зараза стремительно расходится Trichophyton indotineae вызывает красные зудящие высыпания на коже За последние три года случаев заражения стало больше в 500 раз Основные зоны поражения пах бедра и ягодицы Как пояснил эпидемиолог Геннадий Онищенко Абзацу одной из причин распространения таких грибков является безудержное использование антибиотиков они уничтожают нашу нормофлору У нас в кишечнике примерно 2 5 3 килограмма микробов которые нам помогают жить и переваривать пищу Сказать что это будет пандемия нельзя Но то что распространение грибка увеличивается это серьезно рассказал эксперт Подпишитесь на Абзац TG VK Дзен MAX Rutube
Наука88 дней назад

АНЧА БАРАНОВА
В ЕС и США все чаще фиксируют случаи заражения Trichophyton indotineae Это агрессивный грибок который вызывает зудящие красные пятна на коже чаще всего в паховой области на бедрах и ягодицах За последние три года в одной только Великобритании число заболевших выросло почти на 500 Угрозы для жизни нет но лечение может растянуться на долгие недели Откуда появился этот грибок где его можно подхватить и как от него избавиться рассказываю в статье
Наука87 дней назад


Вечерняя Москва
В Европе стремительно распространяется новый новый штамм грибковой инфекции Trichophyton indotineae который уже успели прозвать супергрибком Он поражает паховую область и ягодицы За три года число заболевших выросло на 500 при этом штамм устойчив к привычным лекарствам поэтому победить его довольно сложно Врач инфекционист Елена Мескина объяснила что этот грибок новый вид из группы трихофитонов к которой относятся стригущий лишай и онихомикоз Заразиться можно контактно бытовым путем через предметы поверхность кожи или даже от зараженных собак И хотя чаще случаи встречаются в южных странах распространение в России вполне возможно Симптомы заражения Зуд Жжение Воспаление Шелушение Проблема заключается в том что этот грибок плохо поддается стандартному медикаментозному лечению поэтому человек может испытывать дискомфорт из за неприятных симптомов несколько месяцев Самолечение может оказаться опасным поэтому при первых симптомах лучше сразу обратиться к специалисту Кто в группе риска люди с ослабленным иммунитетом часто болеющие принимающие антибиотики или иммуноподавляющие препараты Подписаться на Вечернюю Москву ВМ в MAX
Наука86 дней назад

URA.RU
В Европе распространяется опасный супергрибок По данным The Sun его название Trichophyton indotineae Инфекция вызывает красные зудящие высыпания в основном в паху на бедрах и ягодицах За последние три года число случаев заражения увеличилось почти на 500 Trichophyton indotineae передается как путем прямого контакта с больным человеком так и через грязные поверхности Заболевание не опасно для жизни но его очень трудно лечить и больным приходится проходить курсы терапии по нескольку недель или даже месяцев Инфекция уже активно передается по территории Британии Франции и Германии а также зафиксированы случаи заражения в США По словам эксперта по инфекционным заболеваниям Манчестерского университета Дэвида Деннинга это станет большой проблемой во всем мире Подписаться на URA RU мы в MAX
Наука89 дней назад


TrendWatching
В Европе началось массовое распространение супергрибка который поражает пах и ягодицы Резкий рост заражения инфекцией trichophyton indotineae зафиксировали в Великобритании и Ирландии Болячка вызывает ужасные зудящие высыпания на коже В основном с паху на бёдрах и ягодицах Инфекция крайне заразная передаётся через кожный контакт но также может распространяться через прикосновение к зараженным поверхностям предметам домашнего обихода или половым путем Самое тревожное что она тяжело поддаётся лечению больные неделями не выходят из дома из за высыпаний Берегите себя и своих близких
Наука88 дней назад


Кровавая барыня
По Европе стремительно распространяется опасный генитальный супергрибок поражающий пах и ягодицы Советую проявить бдительность если планируете предновогодний дейтинг в Европе Некогда редкий вид грибка сейчас стремительно распространяется в Великобритании предупредили эксперты Его можно уничтожить только при помощи токсичной терапии пишет The Sun Грибок вызывает агрессивную красную зудящую сыпь в паху на бедрах и ягодицах Если его не лечить то он распространится и на другие части тела включая лицо Некоторые люди не захотят выходить из дома или ходить на работу Они могут стать изгоями в обществе Если не провести анализы его легко можно спутать с экземой или псориазом предупреждают эксперты За последние три года число случаев трихофитона индийского выросло почти на 500 Ранее об этом грибке в Европе пости не слышали Из за этого сотни людей рискуют стать социальными изгоями предупредил специалист по грибкам из Имперского колледжа Лондона профессор Дариус Армстронг Джеймс Мы не знаем насколько эндемичной или пандемической будет ситуация но уже сейчас растущее число новых пациентов поступающих в больницы вызывает беспокойство В Польше прошла конференция ESCAIDE на которой представили обновленные данные по случаям заражения грибком Они показали что за последние два года число заражений в Великобритании и Ирландии резко возросло с 44 до 2022 года и до 258 по состоянию на март этого года Грибок также известный как T indotineae это разновидность стригущего лишая впервые обнаруженная в Индии в 2014 году С тех пор он мутировал и стал устойчивым к стандартным противогрибковым препаратам Вылечить его можно с помощью многомесячного стационарного лечения итраконазолом препаратом который может вызывать серьезные токсические побочные эффекты в отношении печени и сердца Чиновники системы здравоохранения Великобритании призывают британцев ограничивать контакты кожа к коже
Наука87 дней назад
Похожие новости



+1



+28



+3







+2



+1

Всемирный день борьбы с энцефалитом: важность вакцинации и профилактики
Наука
21 час назад


+1
Сезон активности клещей в Беларуси начинается при 5°C
Общество
1 день назад


+28
Икра горбуши возглавила продажи в России в начале 2023 года
Экономика
1 день назад


+3
Проверки контактных зоопарков в Воткинске и Екатеринбурге выявили серьезные нарушения
Наука
1 день назад



Соболь и олень: необычные события в Саяно-Шушенском заповеднике и на Масленичной ярмарке
Наука
28 минут назад


+2
В Чиангмае зафиксирована массовая гибель тигров: 72 животных погибли от вируса
Наука
1 день назад


+1